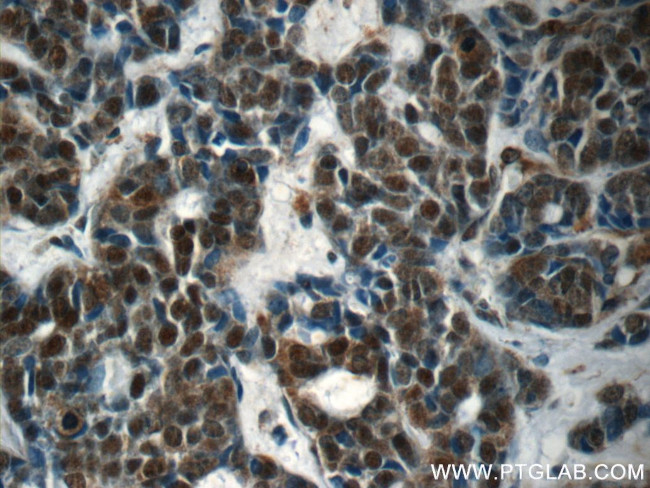
RBM25 Antibody in Immunohistochemistry (Paraffin) (IHC (P))

Search
Proteintech
RBM25 Polyclonal Antibody
{{$productOrderCtrl.translations['antibody.pdp.commerceCard.promotion.promotions']}}
{{$productOrderCtrl.translations['antibody.pdp.commerceCard.promotion.viewpromo']}}
{{$productOrderCtrl.translations['antibody.pdp.commerceCard.promotion.promocode']}}: {{promo.promoCode}} {{promo.promoTitle}} {{promo.promoDescription}}. {{$productOrderCtrl.translations['antibody.pdp.commerceCard.promotion.learnmore']}}
产品信息
25297-1-AP
种属反应
宿主/亚型
分类
类型
抗原
偶联物
形式
浓度
规格
纯化类型
保存液
内含物
保存条件
运输条件
产品详细信息
Immunogen sequence: QKPCLKPTL RPISSAPSVS SASGNATPNT PGDESPCGII IPHENSPDQQ QPEEHRPKIG LSLKLGASNS PGQPNSVKRK KLPVDSVFNK FEDEDSDDVP RKRKLVPLDY GEDDKNATKG TVNTEEKRKH IKSLIEKIPT AKPELFAYPL DWSIVDSILM ERRIRPWINK KIIEYIGEEE ATLVDFVCSK VMAHSSPQSI LDDVAMVLDE EAEVFIVKMW RLLIYETEAK KIGLVK (609-843 aa encoded by BC113389)
靶标信息
RNA-binding protein that acts as a regulator of alternative pre-mRNA splicing. Involved in apoptotic cell death through the regulation of the apoptotic factor BCL2L1 isoform expression. Modulates the ratio of proapoptotic BCL2L1 isoform S to antiapoptotic BCL2L1 isoform L mRNA expression. When overexpressed, stimulates proapoptotic BCL2L1 isoform S 5'-splice site (5'-ss) selection, whereas its depletion caused the accumulation of antiapoptotic BCL2L1 isoform L. Promotes BCL2L1 isoform S 5'-ss usage through the 5'-CGGGCA-3' RNA sequence. Its association with LUC7L3 promotes U1 snRNP binding to a weak 5' ss in a 5'-CGGGCA-3'-dependent manner. Binds to the exonic splicing enhancer 5'-CGGGCA-3' RNA sequence located within exon 2 of the BCL2L1 pre-mRNA. Also involved in the generation of an abnormal and truncated splice form of SCN5A in heart failure.
仅用于科研。不用于诊断过程。未经明确授权不得转售。
生物信息学
蛋白别名: Arg/Glu/Asp-rich protein of 120 kDa; Arg/Glu/Asp-rich protein, 120 kDa; functional spliceosome-associated protein 94; Protein S164; RED120; rna-binding; RNA-binding motif protein 25; RNA-binding protein 25; RNA-binding region (RNP1, RRM) containing 7; RNA-binding region-containing protein 7; U1 small nuclear ribonucleoprotein 1SNRP homolog; unnamed protein product
基因别名: 2600011C06Rik; 2610015J01Rik; A130095G20Rik; AI159652; AL023075; AU043498; fSAP94; NET52; RBM25; RED120; RNPC7; S164; Snu71
UniProt ID: (Human) P49756, (Mouse) B2RY56
Entrez Gene ID: (Human) 58517, (Mouse) 67039